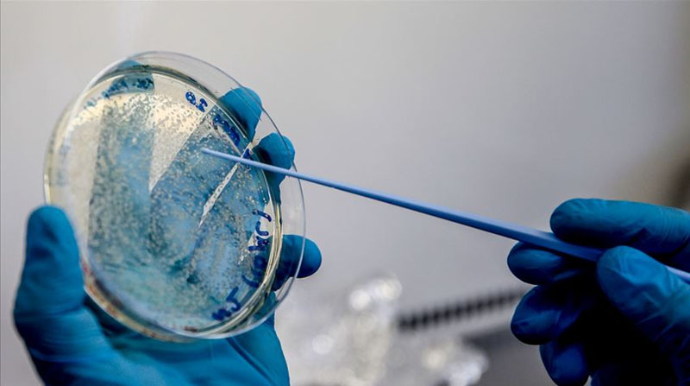
COVİD-19-la bağlı şad xəbər: il sonuna qədər...

COVİD-19-la bağlı şad xəbər: il sonuna qədər...
Avropanın 4 ölkəsi İtaliya, Almaniya, Fransa və Niderland Kovid-19 peyvəndinin hazırlanması üçün ittifaq yaradıb. Bu ilin sonuna qədər Avropa ölkələrinin 400 milyon doz peyvəndlə təmin edilməsi üçün Astrazeneka firması ilə saziş bağlanıb.
Avtosfer.az xəbər verir ki, bu barədə İtaliyanın səhiyyə naziri Roberto Sperenza sosial şəbəkə hesabında məlumat verib. O, sözügedən peyvəndin Oksfordda hazırlandığını, lakin inkişaf etdirilməsi və istehsalına italyan firmalarının töhfəsi olacağını bildirib. Sınaqların payıza qədər başa çatdırılıb, il sonuna qədər paylanması nəzərdə tutulur.
"Bugünkü imza İtaliya və Avropa üçün ümidverici bir addımdır. Peyvənd Kovid-19 üçün yeganə tam həll yoludur. Mən bunu hər zaman qlobal məhsul kimi qəbul edəcəyəm. Bu, hər kəsin haqqıdır. Bir neçə adam üçün xüsusi olaraq hazırlanmayıb", - deyə Sperenza qeyd edib

Bu gün Azərbaycan ərazisində hər qarış torpaq xalqımıza məxsusdur - Prezident - VİDEO

DİN əməkdaşları Heydər Əliyevin xatirəsini yad etdilər - FOTO - VİDEO

SOMDA-da Ümummilli Lider Heydər Əliyevin 103-cü ildönümü münasibətilə tədbir təşkil olunub - FOTOLAR

Yollarda görünüş məsafəsi məhdudlaşacaq - 500-1000 metrədək

Mehriban Əliyeva Zəngilanda çay kənarından paylaşım etdi - FOTOLAR

Özünü pis hiss edən şəhid atasına Prezidentdən xüsusi diqqət - VİDEO

Prezidentin sosial şəbəkə hesablarında Cəbrayıla səfərlə bağlı paylaşım edilib - VİDEO

Laləlikdə maşın sürmüşdülər, polis saxladı - FOTO - VİDEO

Ağdamda yeni tikilən binaların müasir yeraltı dayanacaqları - VİDEO

Ermənistan Cəbrayıla yol çəkmək istəyirdi, vaxtı çatmadı - Prezident

Mehriban Əliyeva Zəngilandan paylaşım etdi - FOTOLAR

















